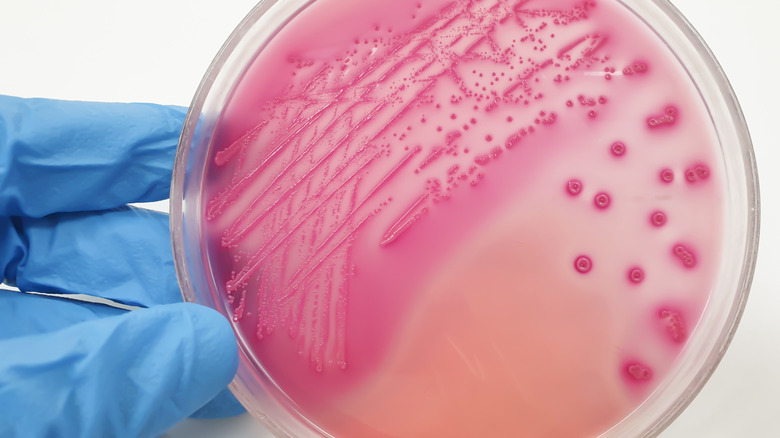

E. Coli Outbreak Linked To McDonald's Quarter Pounders In 10 States
McDonald's lovers should stick to chicken nuggets this week in light of warnings from the FDA of an E. coli outbreak in 10 U.S. states. In addition to the FDA, the USDA, CDC, and health officials at the state and local levels have connected E.coli poisoning to one of McDonald's most iconic burgers: the Quarter Pounder. As more and more reports of food poisoning incidents came to their attention, the common denominator amongst the afflicted was their consumption of Quarter Pounders.
Officials still do not know the exact source of the E. coli, but have narrowed it down to either the beef patties or the slivered onions that come on the McDonald's burger. Both the ground beef and slivered onions are unique to Quarter Pounders; diced onions and beef used on other burgers on McDonald's menu have not been affected according to the FDA.
As tests are run on the ground beef that makes up the Quarter Pounder patties as well as the slivered onions, McDonald's has temporarily suspended the Quarter Pounder ingredients in question in the states where E.coli has been found. The 10 states that have reported cases include: Colorado, Kansas, Utah, Wyoming, Iowa, Missouri, Montana, Nebraska, Wisconsin, and Oregon.
Case counts and other points to consider regarding the McDonald's E. coli outbreak
Part of the investigation into outbreaks of illnesses is a traceback to find where the ingredients were sourced as well as tracking the number of cases and their seriousness. According to the FDA, the onset of E. coli occurred on October 11th. The current case count as of this writing is up to 49 people over the 10 states mentioned above, with Colorado reporting between 10 to 26 victims followed by Utah, Wyoming, and Nebraska with between 4 and 9 victims, while the remaining states have reported between 1 to 3 cases. Of these illnesses, 10 of them required hospitalization while one resulted in death.
The FDA asserts that the case count is probably a lot higher than what has been reported. They also give pertinent information about E. coli and the symptoms it generates in those who are infected with it. While many forms of E. coli are harmless, pathogenic E. coli cause gastrointestinal problems that can, in extreme cases, result in death. While the severity and types of symptoms depend on the type of E. coli, the most at-risk demographic for life-threatening reactions are young children under the age of 5 and older adults above the age of 65. If you have been affected by the outbreak, the FDA urges you to reach out to the contact link on their website.